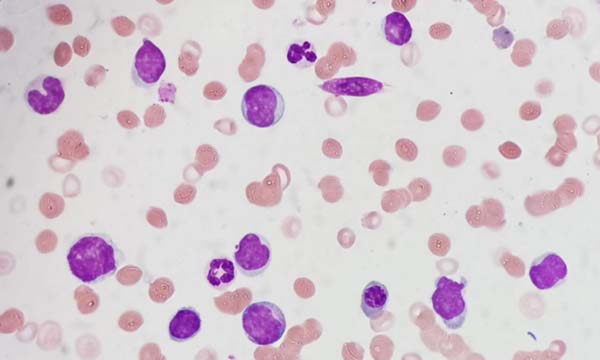
微信图片_20230304131245.jpg
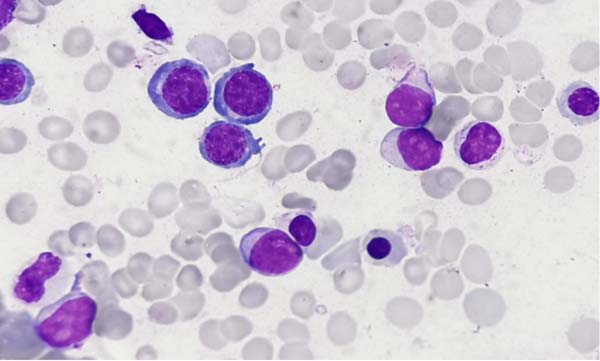
微信图片_20230304131248.jpg

科普文章
别把“白细胞减少”不当回事
血液科门诊常会接诊一些白细胞减少的患者:体检时发现白细胞减少;近期有病毒感染史;恶性肿瘤放化疗史;肝脏病史;结缔组织病史……各自表现不一。那么,白细胞减少常见的原因有哪些呢?

在前几期科普系列讲座中提到,白细胞增多可能是白血病。而在上述白细胞减少的原因中我们可以看到,白细胞减少也有可能是白血病!
我们整理了几例最近我科收治的以“白细胞减少”首诊,最后确诊为急性白血病的病例。
病例1
患者,40岁,职员,因“肢体麻木”就诊,血常规示白细胞减少,血红蛋白、血小板计数均正常;后就诊于北京三甲医院,复查血常规并同时行外周血细胞分类检查,原始细胞25%!完善MICM(骨髓象、免疫分型、染色体、基因)检查确诊为急性髓系白血病,化疗治疗后目前病情稳定。
病例2
患者,35岁,教师,单位体检时发现白细胞减少,详细询问病史,只有乏力表现,虽然血常规提示无贫血和血小板减少,有经验的血液科医生还是给患者做了外周血手工白细胞分类,结果提示原始细胞35%!行MICM检查,确诊为急性髓系白血病,之后给予化疗治疗,并行异基因造血干细胞移植。
病例3
患者,18岁,已经被知名大学录取,开学体检时发现白细胞减少,于三甲医院复查白细胞仍低,外周血分类可以看到大量原始细胞,完善MICM检查确诊急性髓系白血病,化疗治疗后目前病情稳定。

以上几例患者提示:发现白细胞减少要重视,但也不必过度恐慌,毕竟恶性血液病的发病率并不高。发现白细胞减少记得去血液专科就诊,积极寻找白细胞减少原因,同时记得遵医嘱定期随诊。
文章仅用于公益科普及学术交流,部分资料和图片来源于网络,如有侵权,请联系删除。

叶芳,血液内科专家
职称:主任医师
擅长:骨髓增生异常综合征,再生障碍性贫血,淋巴瘤,多发性骨髓瘤,白血病
出诊时间:
①血液内科知名专家门诊:每周二、周四上午(具体时间以当日为准)
②国际医疗门诊:每周一上午(具体时间以当日为准)









 京公网安备11010502033717号
京公网安备11010502033717号